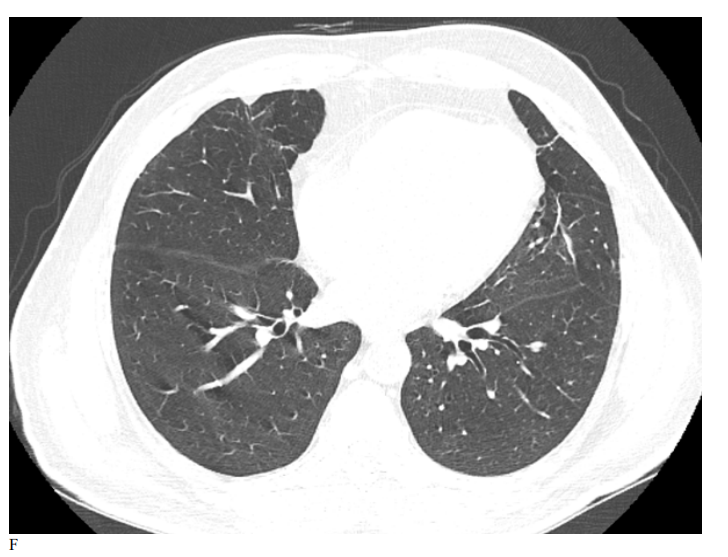

Research Article - (2025) Volume 4, Issue 2
Real Data on Effect of a Combination of Nitazoxanide, Ribavirin and Ivermectin Plus Zinc Supplement on the Clearance of COVID-19 Versus Remdesivir or Favipiravir in Hospitalized COVID Cases
2Associate professor, endemic medicine department, faculty of medicine, Mansoura University, Egypt
3Professor, Department of Public Health and Preventive Medicine, Faculty of Medicine,Mansoura, Mansoura University, Egypt
4Professor, Department of Clinical Pathology, Faculty of Medicine, Mansoura, Mansoura University, Egypt
5Professor, Department of Medical Biochemistry and Molecular biology, Faculty of medicine,Mansoura, Mansoura University, Egypt
6Assistant professor, Department of Clinical Pathology, Mansoura Faculty of Medicine,Mansoura, Mansoura University, Egypt
7Lecturer, Phoniatric Unit, ORL Department, Faculty of Medicine, Mansoura, Mansoura University, Egypt
8Assistant professor, Radiology Department, Mansoura Faculty of Medicine, Mansoura, Mansoura University, Egypt
9Professor, Radiology Department, Faculty of Medicine,Mansoura University, Mansoura, Egypt
10Assistant lecturer at endemic medicine department, Mansoura University, Mansoura, Egypt
11professor, Tropical Hepatogasteoenterology, endemic medicine department,faculty of medicine, Mansoura University, Egypt
12Professor pulmonology, Chest department Mansoura University, Mansoura, Egypt
Received Date: May 16, 2025 / Accepted Date: Jun 18, 2025 / Published Date: Jun 27, 2025
Copyright: ©©2025 Hatem Elalfy MD, et al. This is an open-access article distributed under the terms of the Creative Commons Attribution License, which permits unrestricted use, distribution, and reproduction in any medium, provided the original author and source are credited.
Citation: Elalfy, H., Besheer, H., El-Mesery, A., El-Gilany, A., Alegezy, M., et al. (2025). Real Data on Effect of a Combination of Nitazoxanide, Ribavirin and Ivermectin Plus Zinc Supplement on the Clearance of COVID-19 Versus Remdesivir or Favipiravir in Hospitalized COVID Cases. Arch Epidemiol Pub Health Res, 4(2), 01-08.
Abstract
Background: The pandemic of COVID-19 has forced the health system to incorporate many antiviral drugs into medical field applications. Researchers have started clinical trials to assess the effectiveness of many virus-targeting medications due to the pressing need for a safe and efficient treatment.
Aim: This study examined the the real world data describe effectiveness of nitazoxanide, ribavirin, and ivermectin plus zinc in comparison to those taking remdesivir or favipiravir treatment.
Subject and Methods: Patients inclusion start after approval from Mansoura IRB at April with code number RP.20.05.69. This non-randomized open label-controlled trial included 108 hospitalized patients receiving treatment classified into 3 groups: NRIZ group, favipiravir group, and remdesivir group. They all verified the case with a positive RT-PCR of nasopharyngeal swab.
Results: This trial shows that there are no statistical differences among the 3 groups as regard age, sex, severity, comorbidities, mode of O2 intake, and outcome except for the length of stay at the hospital being lower in the NIRZ group in a Pairwise comparison between the NRIZ group vs. the Remdesivir group (P 0.03).
Conclusion: This trial concluded that NRIZ combination therapy is comparable to either Favipiravir or Remdesivir
Keywords
COVID-19, Antiviral, Hospitalized Cases, Remdesivir, Favipiravir
Introduction
The coronavirus disease 2019 (COVID-19) pandemic, associated with the severe acute respiratory syndrome coronavirus 2 (SARS- CoV-2) virus, continues to pose a threat to the health workforce in many nations worldwide. Furthermore, the virus continues to significantly negatively impact people's lives worldwide [1].
Remdesivir was one antiviral medication that proved beneficial when administered early in the illness. Additionally, remdesivir might be useful in moderate to critical COVID-19: shortening the time to clinical improvement and mortality [2]. Remdesivir had a 94% chance of lowering death in people who need oxygen but are not yet severely ill [3].
Discovered it during their search for influenza-fighting agents [4]. Following its approval and effectiveness in treating influenza in Japan, researchers deemed it a viable agent for use in the 2014 Ebola outbreak in West Africa. It has also been used to treat Lassa fever and norovirus infections [5,6].
Using favipiravir in COVIDâ?19 is not yet widely applied and there is no published data on the serum concentration of favipiravir in the treatment of COVIDâ?19 in vivo (Korula et al., 2024) [1]. As regard safety, it is almost well tolerated except for some gastrointestinal side effects such as nausea, diarrhoea, and abdominal pain [7].
Among the patients of mild and early moderate COVID-19, in comparison to symptomatic therapy, which had a few adverse effects, primarily gastrointestinal distress, and no recorded death during the follow-up period, the combination of nitazoxanide, ribavirin, and ivermectin plus zinc supplement efficiently removed the SARS-CoV2 from the nasopharynx in a shorter amount of time [8].
Study Rationale
There are no previous studies on the real world data that compare the effect of the combination of Nitazoxanide, Ribavirin, and Ivermectin plus zinc supplement (NRIZ) versus the standard of care remdesivir or favipiravir in severe COVID patients who need hospitalization due to their hypooxygenated status.
This study will represent real data on the effect of a combination of nitazoxanide, ribavirin, and ivermectin, plus a zinc supplement, on the clearance of COVID-19 in comparison to remdesivir or favipiravir in hospitalized COVID patients.
Patients and Methods
Study Locality and Duration
The Mansoura University Isolation Hospital of COVID-19 conducted this study between April 2021 and December 2022.
Study Design
NON-RANDOMIZED open label CLINICAL TRIAL
Target Population
Adult patients who exhibit signs and symptoms of probable COVID-19 and whose nasopharyngeal swab RT-PCR results are positive are confirmed to have the virus.
Inclusion Criteria
Aged ≥18 years, patients who require oxygen support, those who are hospitalized, and those who have a laboratory-confirmed SARS-CoV2 infection.
Sample Size
A convenience sample of 108 who completed the study (divided into three groups: favipiravir, remdesivir, and NRIZ groups); all patients were included in the final analysis.
Patients’ Allocation
We used the following criteria to identify patients from hospitalized COVID-positive participants based on their treatment needs. Inclusion Criteria: Aged ≥18 years, laboratory-confirmed SARS- CoV- 2 infection, hospitalized requiring a reservoir mask or high- flow nasal cannula for oxygen support; while exclusion Criteria: Mechanical ventilations for oxygen support, incapacity to take oral medications, and pregnancy or breastfeeding.
After learning about the medications used in each trial arm, the patients signed an informed consent form. Patient were divided into three arms, 2 arms treated according to the last edition of Egyptian protocol for managing COVID. Groups with intermediate need high flow oxygen or just oxygen mask received favipiravir; another more severe group received remdesivir. 3rd arm was our NIRZ group. All 3 groups received supportive medication, fluids, paracetamol, and antibiotics if leukocytosis with neutrophilia or an increase in CRP indicated a bacterial infection, plus steroid in case of severe hypoxia and cytokine storm.
Data Collection
A questionnaire was used to collect:
• Sociodemographic data such as age, sex, place of residence, and occupation.
• Clinical data: signs and symptoms, severity of COVID-19, exposure to a potential source of infection. This study was conducted on patients admitted to hospitals in the COVID area by the following criteria: positive radiological findings, SpO2 ≥ 92% patients (moderate cases) and admitted to the intermediate care unit with SpO2 < 92%, PaO2 /FiO2 < 300, respiratory rate > 30, breaths/min, or lung infiltrates > 50% (severe cases).
• The results of radiography and laboratory tests, along with any associated conditions.
• Follow-up: Every week, the three groups were checked in to repeat RT-PCT, restock medications, and document any side effects.
Treatment
Hospitalized patients were classified into 3 groups of therapy; the favipiravir group received treatment in the form of favipiravir 1600 twice daily in the first day, then 600 mg twice daily, while the remdesivir group was treated with remdesivir 200 mg IV on day 1, followed by 100 mg IV daily for high-risk populations for 5 days that could be extended to 10 days if the response is unsatisfactory. The third group received combined drugs as antivirals: nitazoxanide 500 mg rapid release formula/6 hours, ribavirin 1200 mg (400 mg divided doses); ivermectin in dose 4 tables (24 mg); every day for a week, depending on the individual, all ivermectin dosages were taken once after meals (due to its lengthy half-life of 12 to 54 hours); in addition, 30 mg of zinc supplements were given twice daily.
Follow up for clinical improvement as regard fever and constitu- tional symptoms and laboratory improvement as regard inflamma- tory markers like CRP, leucocytic count, changing swab to nega- tive twice, and later radiological improvement.
Patients’ Adherence
Discussing with the patient directly about their medication-taking habits is the most effective method of evaluating adherence. The project clinical staff follows up with patients in the wards and examines the leftover medications before swabs.
Ethical Consideration
This study was submitted to Mansoura university institutional review board (IRB). The IRB approved the written informed permission of all included patients under code number RP.20.05.69 in April 2021, prior to their inclusion in the trial. Additionally, this study has the ClinicalTrials.gov registration number NCT04959786 at 12/7/2021.
Data Analysis
IBM Corp. published SPSS version 23 in 2015. Version 23.0 of IBM SPSS Statistics for Windows. NY: IBM Corp., Armonk. We used the Shapiro test to check quantitative variables for a normal distribution. We used a one-way ANOVA for group comparison with Bonferroni post hoc multiple comparison, displaying normally distributed data as mean and SD. We employed Kruskal- Walli's test for group comparison using Mann-Whitney post hoc comparison, and displayed non-parametric data as the median (minimum-maximum). We displayed categorical data using numbers and percentages. For group comparison, chi-square, Fisher's exact test, or Monte Carlo test were employed since, when appropriate, P < 0.05 was considered statistically significant.
Results
Sociodemographic data demonstrated in Table 1 shows that there are no statistical differences among the 3 groups as regard age, sex, severity, comorbidities, mode of O2 intake, and outcome except for the length of stay at the hospital being lower in the NIRZ group in a Pairwise comparison between the NRIZ group and the Remdesivir group (P 0.03).
|
|
NRIZ |
FAVIPIRAVIR |
REMDISIVER |
Significance |
Pairwise |
|
(57) |
(23) |
(28) |
(3 groups |
comparison |
|
|
N(%) |
N(%) |
N(%) |
comparison) |
P1/P2/P3 |
|
|
Age in years (mean±SD) |
57.8±13.2 |
58.1±14.5 |
58.7±15.4 |
0.97 |
0.9/0.8/0.9 |
|
Sex: Male |
36(63.2) |
18(78.3) |
16(57.1) |
0.3 |
0.2/0.6/0.1 |
|
Female |
21(36.8) |
5(21.7) |
12(42.9) |
|
|
|
Severity: |
|
|
|
|
|
|
severe* |
52(91.2) |
19(82.6) |
27(96.4) |
0.3 |
0.3/0.7/0.2 |
|
Moderate |
5(8.8) |
4(17.4) |
1(3.6) |
|
|
|
Comorbidities# |
25(43.4) |
8(34.8) |
6(21.4) |
0.13 |
0.5/0.7/0.06 |
|
O2 intake: |
|
|
|
|
|
|
1(1.8) |
3(13.0) |
1(3.6) |
|
|
|
44(77.2) |
15(65.2) |
20(71.4) |
0.7 |
0.08/0.6/0.7 |
|
5(8.8) |
4(17.4) |
5(17.9) |
|
|
|
7(12.3) |
1(4.3) |
2(7.1) |
|
|
|
ICU admission |
12(21.1) |
6(26.1) |
7(25.0) |
0.86 |
0.7/0.6/0.9 |
|
LOS (days) [Median (min-max)] |
8(4-35) |
9(4-27) |
9(5-32) |
0.1 |
0.4/0.03/0.2 |
|
Outcome: |
|
|
|
|
|
|
39(68.4) |
17(73.9) |
19(67.9) |
|
|
|
6(10.5) |
2(8.7) |
4(14.3) |
0.5 |
0.4/0.34/0.2 |
|
2(3.5) |
0 |
3(10.7) |
|
|
|
10(17.5) |
4(17.4) |
2(7.1) |
|
|
Table 1: Demographic, Clinical & Outcome Data of Nriz, Favipiravir and Remdesivir Groups
P1=NRIZ vs. Favipiravir, P2= NRIZ vs. Remdisiver, P3= Favipiravir vs. Remdisiver LOS (length of stay) *One critical case in each group. #Cancer (7), obesity, active HCV, diabetic foot, keto acidosis, cardiac effusion, liver cirrhosis, ascites, chronic kidney diseases and/or dialysis, open cardiac surgery, valve replacement, mesenteric venous thrombosis, hematemesis, liver cirrhosis and hepatoma The pre-treatment CT findings of 3 groups in Table 2 were almost not statistically different as regard pleural effusion, lymphadenopathy, CT. score, and ground glass opacity. Otherwise, consolidation and nodules were more evident in the NIRZ group in a Pairwise comparison between the NRIZ group and the Remdesivir group (P=0.04 and 0.05, respectively). In post- treatment comparisons the NRIZ group is not inferior to the other two groups of antiviral therapy.
|
|
NRIZ N(%) |
FAVIPIRAVIR N(%) |
REMDISIVER N(%) |
Significance (three groups comparison) |
Pairwise comparison P1/P2/P3 |
|
Pre-treatment (on admission) |
|||||
|
Total examined |
53 |
22 |
26 |
|
|
|
Consolidation |
38(71.7) |
18(81.8) |
24(92.3) |
0.1 |
0.36/0.04/0.4 |
|
Nodule |
3(5.7) |
0 |
0 |
0.4 |
0.55/.05/- |
|
Pl. effusion |
14(26.4) |
3(13.6) |
9(34.6) |
0.25 |
0.36/0.5/- |
|
Lymphadenopathy |
21(39.6) |
6(27.3) |
14(53.8) |
0.2 |
0.3/0.23/0.06 |
|
CT. score [Median (min-max)] |
6(2-13) |
7(3-12) |
6(4-18) |
0.89 |
0.6/0.8/1.0 |
|
Ground glass opacity percentage [Median (min-max)] |
30(8-64) |
36.5(7-61) |
24.1(12-88) |
0.83 |
0.9/0.4/0.9 |
|
Post-treatment (at discharge) |
|||||
|
Total examined |
35 |
15 |
22 |
|
|
|
Consolidation |
16(45.7) |
11(73.3) |
15(68.2) |
0.1 |
0.07/0.1/1.0 |
|
Nodule |
2(5.7) |
1(6.7) |
0 |
0.58 |
1.0/0.5/0.4 |
|
Pl. effusion |
6(17.1) |
5(33.3) |
8(36.4) |
0.23 |
0.27/0.1/0.85 |
|
Lymphadenopathy |
6(17.1) |
7(46.7) |
9(40.9) |
0.05 |
0.04/0.05/0.73 |
|
CT. score [Median (min-max)] |
5(1-17) |
8(3-15) |
5(2-15) |
0.3 |
0.01/0.4/0.1 |
|
Ground glass opacity percentage [Median (min-max)] |
18(2-116) |
35(7-81) |
21(9-76) |
0.2 |
0.13/0.2/0.5 |
Table 2: Computed Tomography Finding of the Three Studied Groups (Pre-& Post Treatment)
P1=NRIZ vs. Favipiravir, P2= NRIZ vs. Remdesivir, P3= Favipiravir vs. Remdesivir There are attached three figures 1,2, and 3 of computed tomography of the lung before and after treatment as examples for each group.


Figure 1: Male patient in favipiravir group shows (A) bilateral lung infiltration with areas of ground glass opacities and peripheral pleural based consolidation, Covid severity score 12, Corad 5. (B) After 3 months of therapy, Improvement of bilateral pulmonary infiltrates with residual basal ground glass opacities, Covid severity score 5.


Figure 2: Male patient in remdesivir group shows bilateral ground glass opacities affecting mainly upper lobes and pleural based with small areas of atelectatic bands, Covid severity score 18, while figure D 3 months after treatment shows marked improvement of already present infiltrates with Covid severity score 8.

Figure 3: Male patient in NRIZ group shows diffuse bilateral ground glass opacities with alveolar infiltration mainly lower lobes, Covid severity score 12; while figure E After 03 months treatment shows marked resolutions of pervious bilateral pulmonary ground glass opacities and alveolar infiltrates, Covid severity score 6.
Discussion
In the current study, we explored the effectiveness of favipiravir, remdesivir, and NRIZ in adult patients with moderate-to-sever COVID-19. The results suggest that there are no statistically significant variations in the LOS (length of hospital stay) between the three groups. The outcome (improved no oxygen therapy, home oxygen, residual, chest complications and death).
No statistically significant difference was recorded between groups regarding post-CT findings. However, there were some numerical variations in the lymphadenopathy finding between the three groups, indicating that these variations should be examined in large-scale multicenter trials. These findings suggest that NRIZ might be an effective treatment for COVID-19 among patients who cannot receive favipiravir or remdesivir because these drugs appear to be relatively inexpensive.
The potential use of nitazoxanide, ribavirin, and ivermectin plus zinc was successful in reducing the amount of SARSCoV-2 shedding in nasopharyngeal swabs among mild and early-moderate cases with home therapy in a non-randomized phase I clinical trial compared with routine supportive symptomatic treatment alone, which was created at the initial stages of the pandemic [8].
As of February 28, 2021, an observational study database included 10 986 individuals who have received favipiravir treatment in Japan since March 2020.The National Institute of Allergy and Infectious Diseases' (NIAID) Adaptive COVID-19 Treatment Trial, or ACTT-1, is one of the most important trials. Remdesivir, according to the authors, may reduce the demands on the healthcare system and preserve its resources [9].
Favipiravir is an oral agent that has a well-established safety record and anti-SARS-CoV2 RdRp action in vitro. 10 986 individuals who have received favipiravir treatment in Japan since March 2020 were included in an observational study database as of February 28, 2021. At the 7th and 14th days, the researcher observed that these patients' clinical indicators significantly improved (72.6% and 86.5% in light COVID-19 cases, 63.4% and 77.2% in moderate cases, and 46.6% and 60.4% in severe cases, respectively) [10].
Regarding Remdesivir and Favipiravir's Mechanisms of Action Against COVID-19: Remdesivir was very good at killing SARS-CoV-2 viruses in human lung cells and primary human airway epithelial cultures. Remdesivir's half-maximal effective concentration (EC50) also showed that it could stop the replication of SARS-CoV-2 in a dose-dependent way [11,12]. Favipiravir's strong antiviral action requires a significant and strong suppression of the virus's ability to replicate [13].
Compared to favipiravir or remdesivir, NIRZ has a different mechanism of antiviral action because a NIRZ cocktail of drugs has a critical role in inhibiting SARS-CoV-2 RNA replication through the following: Nitazoxanide may be effective in preventing SARS-CoV-2 reproduction, according to in vitro research, although its practicality in a clinical environment is unclear [14,12]. An analogue of guanosine, ribavirin has a broad- spectrum antiviral impact on both DNA and RNA viruses. The exact way that ribavirin works is still unknown, but two possible explanations are that it stops mRNA capping and causes mutations to happen during viral replication. These systems can lower the viral burden and restrict viral replication [15]. Ivermectin is now a possible therapy option for SARS-CoV-2 after a recent study revealed that the medication inhibited SARS-CoV-2 replication in vitro [16]. Zinc ion (Zn) deficiency, essential for the development and maturity of the innate and acquired antiviral immune response, links immune dysregulation [17].
We have the following study limitations, it is nonrandomized open label study, small sample size, the result need Prospective randomized controlled trials assessing the effectiveness of various medications for more definitive results and it is of single center experience.
In conclusion, concerning hospital mortality, the necessity of ventilation, and the length of hospitalization. This trial concluded that the effectiveness of NRIZ combination therapy is comparable to both favipiravir and remdesivir.
Conclusion
This trial concluded that NRIZ combination therapy is comparable to either Favipiravir or Remdesivir [18,19].
Funding
This study is part of official grant from Mansoura university funding research unit with code number: mu- med-2020-26.
References
- Korula, P., Alexander, H., John, J. S., Kirubakaran, R., & Singh, B., et al. (2024). Favipiravir for treating COVIDâ?19. Cochrane Database of Systematic Reviews, (2).
- Beckerman, R., Gori, A., Jeyakumar, S., Malin, J. J., & Paredes, R., et al. (2022). Remdesivir for the treatment of patients hospitalized with COVID-19 receiving supplemental oxygen: a targeted literature review and meta-analysis. Scientific Reports, 12(1), 9622.
- Lee, T. C., Murthy, S., Del Corpo, O., Senécal, J., & Butler- Laporte, G., et al. (2022). Remdesivir for the treatment of COVID-19: a systematic review and meta-analysis. Clinical Microbiology and Infection, 28(9), 1203-1210.
- Furuta, Y., Gowen, B. B., Takahashi, K., Shiraki, K., & Smee,D. F., et al. (2013). Favipiravir (T-705), a novel viral RNA polymerase inhibitor. Antiviral research, 100(2), 446-454.
- Raabe, V. N., Kann, G., Ribner, B. S., Morales, A., & Varkey,favipiravir treatment. New England Journal of Medicine, 379(22), 2173-2176.
- Ruis, C., Brown, L. A. K., Roy, S., Atkinson, C., & Williams,R., et al. (2018). Mutagenesis in norovirus in response to
- Chiu, M. N., Bhardwaj, M., & Sah, S. P. (2022). Safety profile of COVID-19 drugs in a real clinical setting. European journal of clinical pharmacology, 78(5), 733- 753.
- Elalfy, H., Besheer, T., Elâ?Mesery, A., Elâ?Gilany, A. H., & Soliman, M. A. A., et al. (2021). Effect of a combination of nitazoxanide, ribavirin, and ivermectin plus zinc supplement (MANS. NRIZ study) on the clearance of mild COVIDâ?19. Journal of medical virology, 93(5), 3176-3183.
- Beigel, J. H., Tomashek, K. M., Dodd, L. E., Mehta, A. K., & Zingman, B. S., et al. (2020). Remdesivir for the treatment of Covid-19. New England Journal of Medicine, 383(19), 1813- 1826.
- Doi, Y. K., Ando, M., Kuwatsuka, M., & Ishihara, Y. (2021). Favipiravir Observational Study Interim Report 3. Observational Study Group, Fujita Health University: Aichi, Japan.
- Pruijssers, A. J., George, A. S., Schäfer, A., Leist, S. R., & Gralinksi, L. E., et al. (2020). Remdesivir inhibits SARS- CoV-2 in human lung cells and chimeric SARS-CoV expressing the SARS-CoV-2 RNA polymerase in mice. Cell reports, 32(3).
- Wang, M., Cao, R., Zhang, L., Yang, X., & Liu, J., et al. (2020). Remdesivir and chloroquine effectively inhibit the recently emerged novel coronavirus (2019-nCoV) in vitro. Cell research, 30(3), 269-271.
- Naesens, L., Guddat, L. W., Keough, D. T., Van Kuilenburg,A. B., & Meijer, J., et al. (2013). Role of human hypoxanthine guanine phosphoribosyltransferase in activation of the antiviral agent T-705 (favipiravir). Molecular pharmacology, 84(4), 615-629.
- Cao, J., Forrest, J. C., & Zhang, X. (2015). A screen of the NIH Clinical Collection small molecule library identifies potential anti-coronavirus drugs. Antiviral research, 114, 1-10.
- Crotty, S., Cameron, C. E., & Andino, R. (2001). RNA virus error catastrophe: direct molecular test by using ribavirin. Proceedings of the National Academy of Sciences, 98(12), 6895-6900.
- Caly, L., Druce, J. D., Catton, M. G., Jans, D. A., & Wagstaff,K. M. (2020). The FDA-approved drug ivermectin inhibits the replication of SARS-CoV-2 in vitro. Antiviral research, 178, 104787.
- Overbeck, S., Rink, L., & Haase, H. (2008). Modulating the immune response by oral zinc supplementation: a single approach for multiple diseases. Archivum immunologiae et therapiae experimentalis, 56, 15-30.
- Bai, C. Q., Mu, J. S., Kargbo, D., Song, Y. B., & Niu, W. K.,et al. (2016). Clinical and virological characteristics of Ebola virus disease patients treated with favipiravir (T-705)—Sierra Leone, 2014. Clinical Infectious Diseases, 63(10), 1288-1294.
- Jacobs, M., Aarons, E., Bhagani, S., Buchanan, R., & Cropley, I., et al. (2015). Post-exposure prophylaxis against Ebola virus disease with experimental antiviral agents: a case-series of health-care workers. The Lancet Infectious Diseases, 15(11), 1300-1304.

